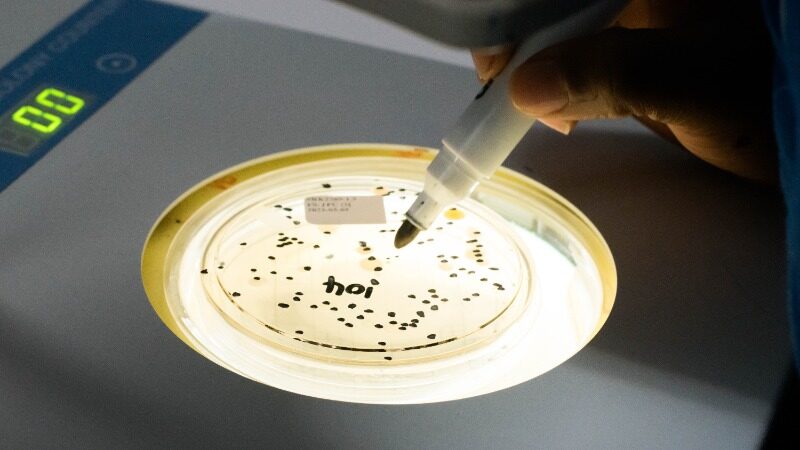
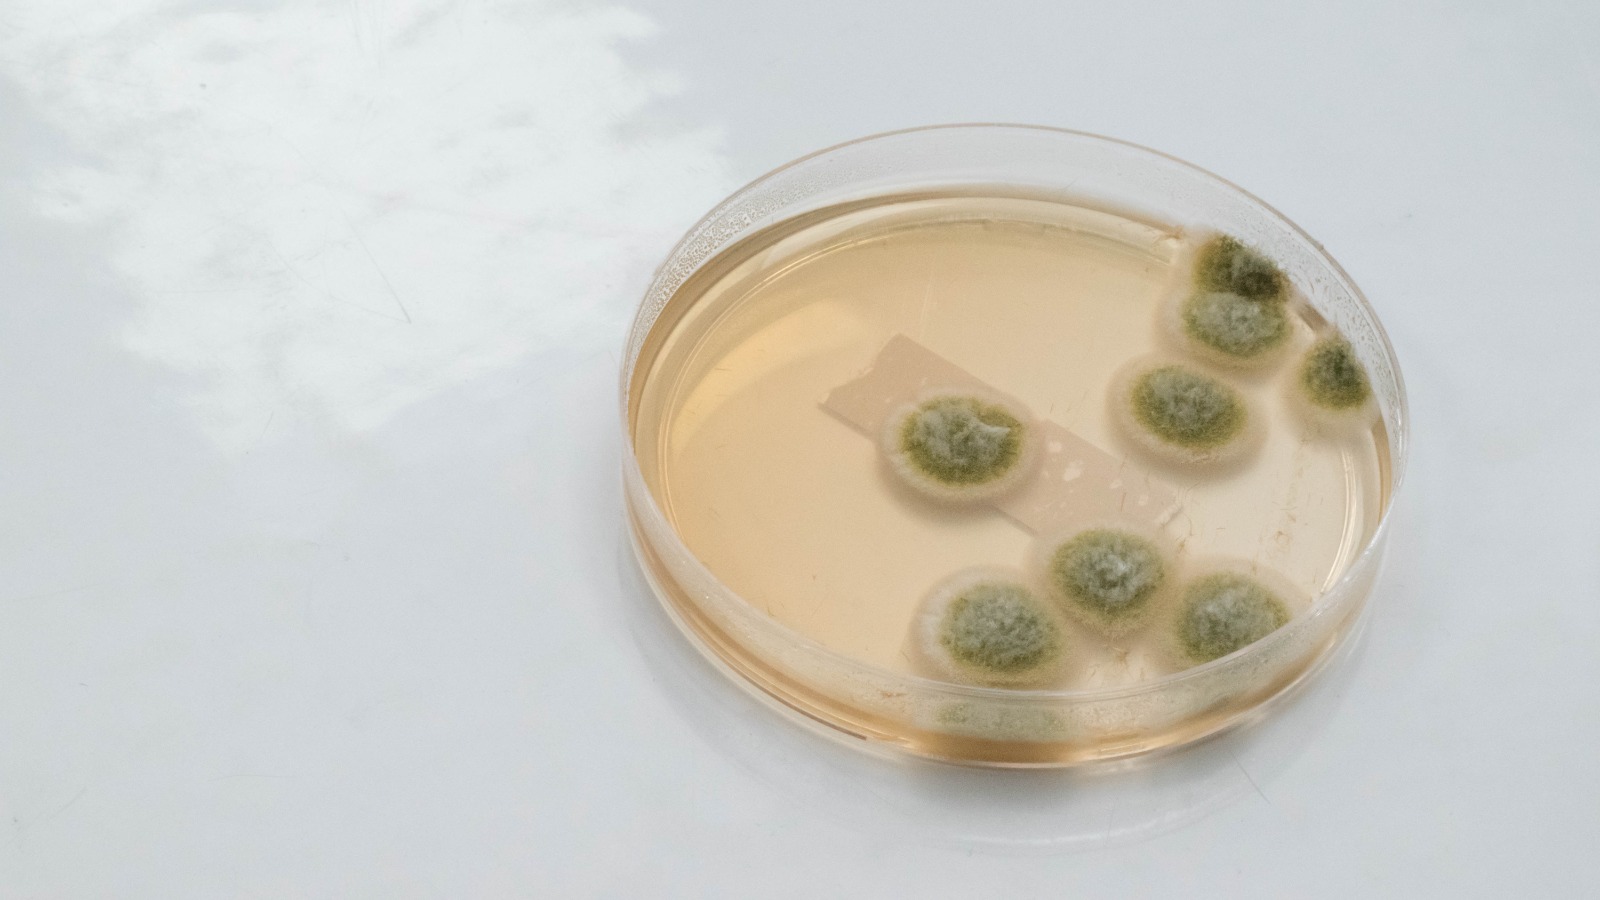

Services
Hygiene & Product Monitoring
Accredited testing for agricultural environments.
Our hygiene and product monitoring services identify microbial contamination in air, water, surfaces, and farm environments, helping protect flock health, reduce pathogen spread, and maintain biosecurity compliance.
SMT VET provide an extensive range of methodologies, such as:
Air plates:
- Total Plate Count
- Yeast and Mould
- Aspergillus species Count (Unaccredited)
Contact paddles/plates
- Total Plate Count
- Yeast and Mould
- Aspergillus species Count (Unaccredited)
Swabs
- Total Plate Count
- Yeast and Mould
- Salmonella species Detection
- Aspergillus species Count (Unaccredited)
Product
- Total Plate Count
- Yeast and Mould
- Salmonella species Detection
- Aspergillus species Count (Unaccredited)
Water
- Total Plate Count
- Yeast and Mould
- Salmonella species Detection
- Coliforms
- Enterococci species
- Escherichia coli
- Faecal Coliforms
- Pseudomonas aeruginosa
- Pseudomonas species
- Water pH at 25°C (Unaccredited)
Salmonella species Serotyping
- Check and Trace
- Kauffman-White Le-minor Scheme
Other:
- Bacterial eggshell count (Unaccredited)
- Aspergillus spp. Count on eggshells (Unaccredited)
- Bacterial Yolk Sac count Test (Unaccredited)

Why Choose SMT VET
Industry-Leading Speed
Results in as little as 3 days for positive release, consistently beating average turn-around times.
Trusted Accreditation
SANAS accredited and DAH approved, ensuring full compliance.
True Partnership
Nation-wide footprint with personal, expert support whenever you need it.
Get Started
Request a Quote Today
Fast, accredited testing tailored to your needs.
Our team will guide you to the right methods and provide clear turnaround times.



